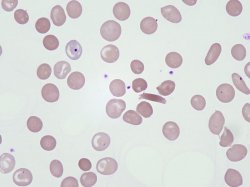
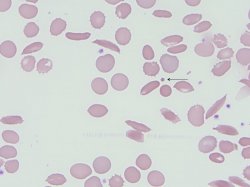

Anemia Falciforme: Entendendo a Doença que Transforma o Sangue em Desafios!
png.jpg)
A anemia falciforme é uma condição genética hereditária que afeta a estrutura da hemoglobina, que responsável por carregar oxigênio para todo o corpo. Na anemia falciforme, uma mutação transforma a hemoglobina em vilã, levando as hemácias a assumirem o formato de uma foice ou meia-lua. Mas o problema não para no formato: essas células se tornam rígidas e propensas a causar caos nos vasos sanguíneos.
O Que Acontece no Sangue?
Vamos falar de fisiopatologia– o alicerce de qualquer análise clínica bem feita. Tudo começa com uma mutação no gene da beta-globina, onde um inocente ácido glutâmico é substituído por uma valina. Parece uma troca simples, certo? Mas esse pequeno detalhe causa uma verdadeira revolução (ou melhor, confusão) dentro do organismo, pois essa hemoglobina com a troca tem um problema sério: POLIMERIZA EM BAIXAS TENSÕES DE OXIGÊNIO! E com isso temos:
- Oclusão vascular: Os glóbulos em forma de foice se acumulam, bloqueando vasos sanguíneos e causando isquemias. Resultado? Dor intensa e danos aos tecidos.
- Hemólise: Células falciformes têm uma vida útil curtíssima. Enquanto um glóbulo vermelho saudável vive cerca de 120 dias, os falciformes sobrevivem só 20 dias. Isso causa anemia crônica.
- Inflamação crônica: O ciclo de oclusão e hemólise ativa respostas inflamatórias que perpetuam o dano.
Como a Doença se Manifesta?
A anemia falciforme não segue um roteiro previsível; ela pode se manifestar de formas muito variadas. Veja os principais sinais e sintomas:
- Crises vaso-oclusivas: Episódios de dor intensa, especialmente nos ossos e articulações.
- Anemia crônica: Proporciona aquele combo de cansaço, fraqueza e palidez que os pacientes não esquecem.
- Síndrome torácica aguda: Dor no peito, falta de ar e febre – uma emergência médica.
- Acidente vascular cerebral: Sim, até o cérebro pode entrar nessa dança perigosa.
- Infectividade aumentada: Devido à perda funcional do baço, o risco de infecções graves, como pneumonia, é alto.
- Danos orgânicos: Rins, fígado, baço e outros órgãos podem sofrer danos ao longo do tempo.
Diagnóstico: Onde nós entramos em ação!
Para diagnosticar a anemia falciforme, é essencial juntar as peças do quebra-cabeça clínico e laboratorial. Aqui estão os passos mais comuns:
1. Histórico familiar: Um simples "alguém na família tem a doença?" pode direcionar o raciocínio.
2. Exame físico: Olhe para os sinais: palidez, icterícia, esplenomegalia.
Exames laboratoriais: A cereja do bolo.
O
O hemograma cursa com uma anemia normocítica e normocrômica, em algumas situações podendo ser macrocítica pela quantidade de reticulócitos.
Se for uma doença falciforme associada com talassemia, o hemograma terá uma anemia microcítica e hipocrômica.
Na lâmina encontramos achados hemolíticos como:
-policromasia
-esferócito
-codócitos
-DREPANÓCITOS - esse é patognomônico da doença
Exames confirmatórios:
-Eletroforese de hemoglobina: Identifica a presença da hemoglobina S.
(o teste de falcização que era utilizado amplamente hoje esta em desuso, sendo substituido pela eletroforese)
- Também é possivel testes moleculares para identificar a mutação de modo direto!
Conclusão
Para os analistas clínicos, compreender a doença não é apenas uma questão técnica, mas uma missão de impacto real na vida de quem depende do nosso trabalho. Estar atento aos sinais, compreender os processos e agir com precisão pode fazer toda a diferença.
Quer continuar mergulhando no mundo da hematologia de alta complexidade? Fique por aqui e descubra como transformar seus diagnósticos em um verdadeiro diferencial clínico. Afinal, no mundo da saúde, conhecimento nunca é demais! 🚀
Conheça nosso treinamento Hematologia Prática clicando AQUI
Gostou do nosso conte�do?
Cadastre-se para receber nossos conte�dos exclusivos.